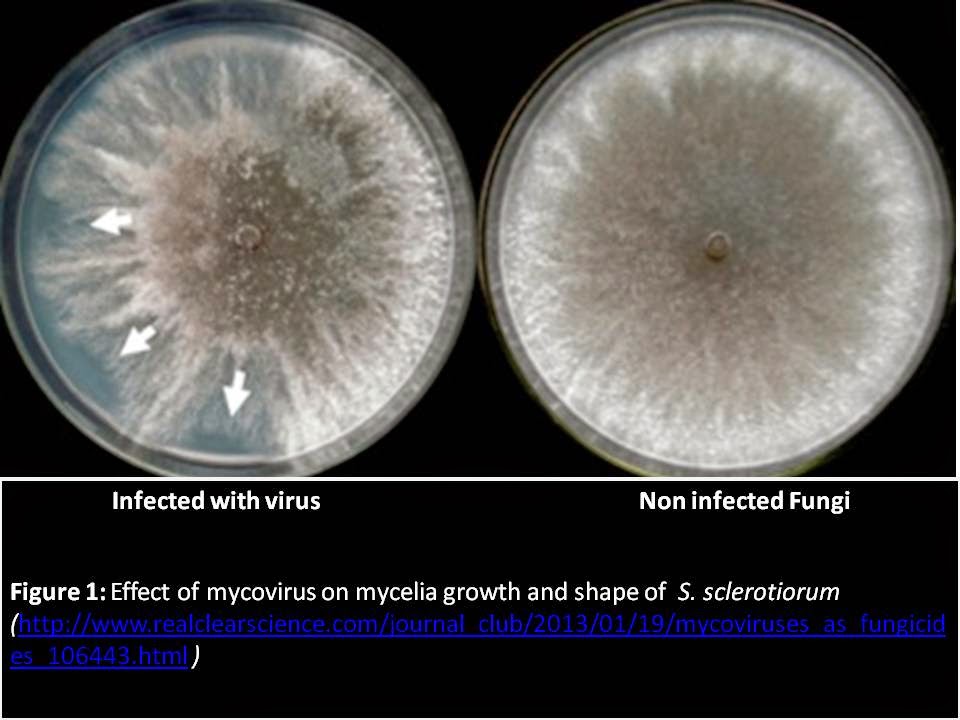
A Comprehensive Review On Mycoviruses As Biological Control Agent

In addition to the information above, here is a curated collection of images related to Fluid Around Lung Ct Scan.
- Fluid Around Lung Ct Scan
- Ct Chest With Dense Fluid Collection In Right Lung. | Download ...
Mores | Update Everything
In addition to the information above, here is a curated collection of images related to Fluid Around Lung Ct Scan.
Explore exclusive offers, detailed information, and related services about fluid around lung ct scan from our trusted partners.
View Special Offers
Source: radiologykey.com

Source: img.medscapestatic.com

Source: d16qt3wv6xm098.cloudfront.net

Source: f6publishing.blob.core.windows.net

Source: www.mdpi.com

Source: cdn.mdedge.com

Source: www.ajronline.org

Source: pubs.rsna.org

Source: prod-images-static.radiopaedia.org

Source: child-foundation.org

Source: www.pockethealth.com

Source: www.radiologymasterclass.co.uk

Source: theijcp.org

Source: sciresol.s3.us-east-2.amazonaws.com

Source: post.medicalnewstoday.com

Source: www.researchgate.net

Source: radiologykey.com

Source: storage.googleapis.com

Source: www.tau.ac.il

Source: media.sciencephoto.com

Source: media.post.rvohealth.io

Source: thecommonvein.com

Source: c8.alamy.com

Source: www.researchgate.net

Source: www.radiologycafe.com

Source: www.researchgate.net

Source: img.medscapestatic.com

Source: www.thoracic.org

Source: www.radiologycafe.com

Source: www.childrensmercy.org

Source: storage.googleapis.com

Source: radiologykey.com

Source: www.verywellhealth.com

Source: www.ajronline.org

Source: ctisus.com